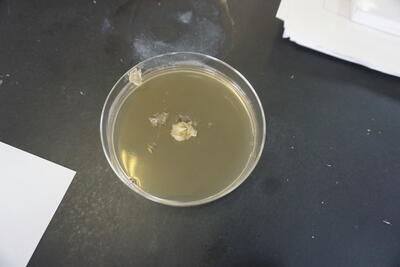

八農ブログ
草木染にチャレンジ!
3年福祉家庭科です!
住生活デザイン選択者で、草木染をしました。
農場で栽培されている、マリーゴールド、サルビア、先日食文化チームで使用したよもぎを活用して、染色しました。

植物の繊維が入りやすくするように、たんぱく質につけて下準備します。今回は、豆乳に浸しました!


ステンレス鍋に花と水を入れ、沸騰させて染液を作ります!さらに、染色できるよう媒染液も作ります。今回は、ミョウバンを使用しました。


模様をつけるための絞りを入れ、浸していきます。


水洗いし、脱水したら完成!


日本文化を今後も継承していきたいですね!
「爆裂種」!?を使ったポップコーン作り!
3年福祉家庭科です!
先日、「食文化」選択者でよもぎ餅を作りました。
実はその際、農場の先生からポップコーン用の「爆裂種」というトウモロコシをいただいたのです!
よもぎ餅作りと並行して調理していきます・・・!

その名の通り、フライパンの中でパチパチと音を立て、爆裂(笑)しながら完成しました
少し焦げましたが、バターの良い香りが2階まで広がっていたようです よく出来ましたね
様々な品種も勉強しながら調理していきましょうね!
よもぎ餅を作りました!!
3年福祉家庭科です!「食文化」という科目の選択者6名で、よもぎ餅を作りました。
まずは、農場の奥にある田んぼまでよもぎ摘みへ・・・
調理室へ移動し、よもぎを洗浄、重曹を入れたお湯で消毒します。すり鉢で細かくし、よもぎの準備完了です!
いよいよ餅づくりへ!白玉粉、上新粉、砂糖、よもぎを混ぜて電子レンジで温めます。蒸し器でもOK!
だまが残り苦戦中・・・ガンバレ~!
餅がまとまったら、丸めた餡を包みます。片栗粉を付けて丁寧に形成します。
完成しました!ジャーン!綺麗に形成できています
季節や行事に合わせた調理実習。今後も、農場に足を運びながら食文化を学んでいきましょうね
子育て支援センター交流会
3年福祉家庭科(2限)、2年家庭科(4限)「保育基礎」の時間に鏡子育て支援センターの先生方に来校していただき、交流会を実施しました。第1回目は子育て支援センターについての講話とおもちゃ作りでしたまず、子育て支援センターについての説明や保育園の様子、保育士のやりがいなどについてお話がありました。
「子どもって本当にかわいい!」という言葉が印象的でした。保育園や支援センターでは、一人ひとりの子どもがとても大切な存在で愛情いっぱい保育をされていることが伝わってきました。
その後、おもちゃ作りを行いました。今日作るおもちゃは・・・
ペットボトルのキャップやビニール、輪ゴムなど身近な材料を使って、みんなで楽しく作りました。
「失敗してもいいんだよ」「いろんな金魚がいていいんだよ」という温かい言葉に包まれて
みんなニコニコ笑顔で思い思いの金魚を完成させました。
昼休みはきっと教室で楽しく遊んでいることでしょう
今日の感想には「初めて子育てをする人や不安や心配事があるお母さんたちがいつでも相談できる場所があることがいいなと思います」「子どもの遊び道具なので食べないようにしっかり固定したり工夫して作るのが楽しかったです」などがありました。
子育て支援センターの先生方、大変お世話になりありがとうございました。
校内農業鑑定競技会が行われました。
本日、農業鑑定競技会が行われました。
農業鑑定競技とは、年に一度行われる全国大会を目指して自分の持っている知識や技術を競い合うものです。
自分の所属している学科の専門分野で学ぶ区分に取り組んでいます。
問題には、実物や写真などが置いてあり、その名称や特徴、使い方などを答える競技です。
また、問題の中には農業で使う計算問題など難しいものもあります。
そのため身に付いた知識や技術が必要です。
1年生にとっては、初めての鑑定競技会でした。
皆さんいかがだったでしょうか?
校内の農業クラブの役員の皆様、準備お疲れさまでした
2年家庭科「生活と福祉」
2年家庭科「生活と福祉」の授業で「バイタルチェック」の実技練習を行いました。
利用者役と介護者役に分かれて、練習を行います。
脳出血による左上下肢まひのある高齢者を想定して、寝たままの状態で体温を測ったり、脈拍を測ったりしました。
利用者に安心感を与え、負担の少ない介護をめざして練習しました。
家庭科「保育基礎」造形表現活動
「保育基礎」の授業では、時々、折り紙などを使って造形表現活動を行っています。
5月は折り紙を使って、「あじさい」を作りました。
活動のねらいは以下の通りです。
・紙を丸める、折り紙を折る、切るなど指先の動きの発達
・色や柄、形、大きさなど自由に個性を表現する
・共同制作や人との交流を楽しむ
それぞれの生徒が周りの友達と協力しながら、個性的なあじさいの花を作っていました。
家庭クラブ総会を行いました。
5月21日に福祉家庭科・家庭科では、家庭クラブ総会を行いました。
昨年度の会務報告や決算報告、今年度の事業案、予算案、規約改正など様々な協議がありました。
1年生は初めての参加でしたが、八農の家庭クラブについて少し理解が深まったかなと思います。
今年もお菓子作り講習会など、楽しい行事も企画していきますので、ぜひみんなで家庭クラブ活動を盛り上げていきましょう。
3年福祉家庭科 子どもシャツ製作
3年福祉家庭科「ファッション造形」の授業では、7月の被服検定2級受験に向けて半袖シャツ製作を行っています。被服検定2級(洋服)では、3時間で半袖シャツの製作を行います。
1回目の練習では子どもサイズのシャツを作りました。裁断、しるしつけ、端の始末、本縫い、仕上げ・・・
かなり多くの時間と労力をかけてシャツを作り上げます。
検定の評価基準はきびしいので、縫い目がずれたりゆがんだりしないように、真剣に製作に取り組んでいます。
ようやくできあがりました。小さい子どもに着せるのが楽しみですね。
検定本番は大人サイズのシャツを製作します。がんばりましょう!
5月の誠勤礼タイム
本日、午後に体育館で誠勤礼タイムが行われました。
今回の講演の講師は、桑島先生でした。
講演では、「ルールを守ること」について話がありました。
最後にお礼の言葉を3年食品科学科の村田さんが行いました。
桑島先生、本日は講演頂きありがとうございました。
令和6年度 総体推戴式
5月24日(金)、生徒総会の後に総体推戴式が行われました。
まず、川邊教頭より総体に出場する選手へ激励の言葉があり、
その後、選手宣誓を3年食品科学科の宮﨑さんが行いました。
福祉家庭科3年生の河本さんより選手の皆さんへ応援のメッセージがあり、
各部活動からは、意気込みと試合会場などの紹介がありました。
いよいよ総体が始まります。選手の皆さん悔いのないようがんばってください。
令和6年度 生徒総会
5月24日(金)に生徒総会が行われました。
様々な意見もあり、多くの人が学校についてよく考えていることが分かりました。
今後も八代農業高校が良くなるようみんなでがんばりましょう。
愛鏡祭が行われました
本日、鏡文化センター周辺で愛鏡祭が行われました。
食品科学科から、マーマレードと万能タレを販売させて頂きました。
天気も良く、多くの来場者があり、販売物も全部売り切れました。
愛鏡祭の関係者の皆様、本日は良い機会を頂きありがとうございました。
また、わかあゆ高校の皆様も隣で一緒に活動させて頂き、ありがとうございました。
八代市長表敬訪問
5月24日(金)に、本校のマーマレードを用いた地元企業との商品化についての紹介のため、
八代市役所に本校の生徒と商品開発を行なった地元企業の方々と共に市長訪問に行きました。
開発をされた企業は、八代市のミカエル堂、ミルキー、氷川町の園田製菓(敬称略)です。
本日は、お忙しい中八代市役所にお招き頂きありがとうございました。
また、地元企業の皆様もいつもご協力いただきありがとうございます。
令和6年度 八代農業高校農業クラブ総会
本日、体育館で農業クラブの総会が行われました。
農業クラブのオリエンテーションと予算等の報告、意見交換などが行われました。
農業クラブ役員の皆さん、準備から総会の進行までお世話になりました。
1年食農創造科 アレンジ絞り出しクッキー
1年食農創造科の生徒が、絞り出しクッキーを作りました。
今回は、ココアクッキーか抹茶クッキーを選び、班で協力して最初から製造しました。
絞り出した後、オーブンで焼きます。
無事に出来上がりました。
様々な形のクッキーが焼きあがりました。
2年食農創造科 ミルクパン製造実習
2年食農創造科の生徒が、食品製造の授業でミルクパンを作りました。
パンの製造は、2年生になって初めて行われます。
おいしく焼き上がりました
焼き上がりの後は、みんなで試食をしました。
焼き上がりが一番おいしかったようです。
日奈久カーネーション祭りに参加してきました
日奈久温泉で行われた日奈久カーネーション祭りに本校の生徒が参加してきました。
また、このイベントのために開発したマフィン等を販売しました。
天気があまり良くなく、例年に比べて来場者は少なかったですが、イベント会場は盛り上がっていました。
日奈久のイベント関係の皆様、貴重な経験をさせて頂きありがとうございました。
令和6年度 PTA総会が行われました
本日PTA総会が行われました。
まず、体育館でポスターセッションが行われました。
その後、2時間目は授業参観です。
授業参観後PTA総会が行われました。
総会後、学級懇談が行われ、PTA各委員会の打ち合わせ会が行われました。
保護者の皆様、本日はお忙しい中PTA総会に参加いただきありがとうございました。
今年も本校のPTA活動へのご理解とご協力をよろしくお願いいたします。
1年食品製造 絞り出しクッキー
1年食農創造科の生徒が食品製造の授業で、初めて製造室での実習を行いました。
初めての食品製造の実習で、先生の手本を参考にクッキーを絞っていきます。
様々な大きさのクッキーが焼き上がりました。
焼けた後は、クッキーを袋につめて、試食を行いました。
小学生交流学習小学生(さつまいも)
今回は鏡小1年生と、本校の食農創造科1年生でサツマイモの定植をしました
本校のお兄さん、お姉さんに教えてもらいながら楽しく定植していました
天気も良く楽しく交流出来たと思います
これから植物が成長する様子を小学生の皆さん見に来てもらえるといいです
学習サポーター新任式
本日、学習サポーターを担っていただく先生の新任式が行われました。
まず、吉田校長先生より新任者紹介が行われました。
本日からご勤務いただく米村先生から挨拶をしていただきました。
その後在校生歓迎の言葉を食品科学科3年の山村さんが行いました。
学習サポーターを担って頂く米村先生、八代農業高校をよろしくお願いいたします。
令和6年度 農業クラブ校内意見発表会
農業クラブ校内意見発表会が体育館で行われました。
農業クラブ校内意見発表会式次第
1 開会
2 農ク会長挨拶 3年食品科学科 大庫さん
3 成人代表あいさつ 吉田校長先生
4 発表上の注意 3年食品科学科 古川さん
5 審査員紹介 農場長、各科主任
6 発 表 発表題 学年・クラス 名前
① 私の夢 3年園芸科学科 小畑さん
② これからの高校生活を送るうえで 1年生産土木科 倉井さん
③ 「農業ってキツイ」から見つけた私の未来 2年食農創造科 津々路さん
④ 私たちが受け継いでいくもの 2年生産土木科 福浦さん
⑤ 食品ロスについて 3年食品科学科 出田さん
⑥ スマート農業について 3年農業工学科 田中さん
⑦ 地域の未知なる可能性を信じて 2年食農創造科 大田さん
7 講 評 福嶋農場長
8 閉 会
発表者の皆さん、短い準備期間の中、発表お疲れさまでした。
ドローンの操縦準備完了❕
生産土木科1年の未来探究の授業でドローンのアプリをダウンロード
練習機との接続確認を実施
本日は雨天のため、実際に飛行はできませんでした
天候が良い日に改めて、ドローンを使って画像・動画・点群を取得します
令和6年度 体育大会②
4月27日(土)雨の影響で13:00からでしたが、令和6年度体育大会を開催することができました。
急遽の変更にもかかわらずたくさんの保護者等にご来場頂き、ありがとうございました。
今回は、当日の様子をもう少し詳しく紹介します。
午前中
今年の体育大会についての説明や校長先生による激励の挨拶等が行われました。
一部競技を開始するため、ラジオ体操行いました。
大縄跳び
13時から開会式を行い競技開始です
最初は「追っかけ玉入れ」です
竹取競争
宅配リレー
二人三脚リレー
リズムなぎなた
綱引き
俵差し
50M走
団対抗リレー
閉会式
令和6年度 体育大会
本日、八代農業高校の体育大会が行われました。
朝の雨の状況で、1部変更して13:00~開始されました。
青団と緑団に分かれて白熱した戦いが行われ、競技も盛り上がっていました。
そして最後に、解団式と片付けまでみんなで行いました。
本日は、急遽計画の変更があり、ご来場いただいた保護者の皆様を初め来場者の皆様方には、
ご迷惑をおかけしました。
13:00~の開始でしたが、多くの方にご来場頂き、ありがとうございました。
生徒たちも、一生懸命頑張り、思い出に残る体育大会になりました。
また、来週からがんばりましょう。
お疲れさまでした。
体育大会練習最終日
本日も体育大会の練習が行われました。
まずグラウンドに集合後、体育大会本番に向けて、係打合せや椅子の準備等、最後の準備を行いました。
その後、各団に分かれて、競技練習を行いました。
午後からは、体育館で各団応援練習など最後の確認を行っていました。
明日はいよいよ体育大会当日です。
生徒の皆さん、明日は素晴らしい体育大会になるように体を休めて、明日に備えましょう。
明日の体育大会について・・・
現時点では、予定通り開催する予定です。
最終判断は、4月27日(土)午前6時に行い、午前6時20分までにはホームページのトップページに掲載しますので、よろしくお願いします。
体育大会予行練習が行われました
本日、体育大会の予行練習が行われました。
今週初めての晴天となったので、まずはテントの設置です。
リーダーの生徒たちが中心となり、各団ごとにテント設営を行いました。
テント設置が終わり、予行練習が始まりました。
また、各競技について確認をしっかり行いました。
今週は、雨天続きでグラウンドが使えず、久しぶりの外での活動でした。
日差しも強く大変暑い中での予行練習となり、生徒たちも大変疲れていました。
体育大会はもうすぐです。体調管理に気を付けて、良い体育大会になるようにみんなでがんばりましょう。
生産土木科・農業工学科の意見発表校内予選会!
本日、生産土木科・農業工学科の意見発表会を実施しました
4名の生徒がクラスの代表として自分の農業に対する思いを発表してくれました
どの発表もしっかりとした意見があり、堂々とした発表でした
5月1日の校内大会に向けてこれからもしっかり練習に取り組んでください
<出場者>
生産土木科1年 倉井さん
生産土木科2年 福浦さん
農業工学科3年 田中さん
農業工学科3年 渡辺さん
今回、代表に選ばれなかった皆さんもその他の活動で全国大会を目指しましょう
八農マーマレード発売開始!!
本日より、八代農業高校マーマレードを販売しています。
昨年、ダルメイン世界マーマレードアワード&フェスティバルで銀賞を受賞した商品です。
学校の事務室前で販売しております。
皆様よろしくお願いします。
体育大会結団式~青団~
本日、体育館で体育大会の結団式が行われました。
青団でも、各クラスのリーダー紹介が行われました。
その後、円陣を組み青団としての団結を高めていました。
練習期間はあまりありませんが、良い体育大会になるようみんなでがんばりましょう。
体育大会結団式~緑団~
3限目の時間に体育大会の結団式がありました
緑団のリーダーや各クラスのリーダーより所信表明がありました
リーダーから話しをした後に、円陣を組み決意を確認しました
今週は雨の日や曇りの日が多いみたいですでも、気温は高くなるので熱中症や気圧の変化で体調を崩さないようにしましょう
ケガをしないように頑張りましょう
令和6年度(2024年度)防災(地震・津波)避難訓練
4月18日(木)に防災避難訓練が行われました。
今回の訓練では、地震後津波が発生するという想定で避難訓練が行われました。
地震発生後、1次避難としてグラウンドに避難しました。
その後、津波が発生したという想定で2次避難で校舎の一番高い階に移動しました。
地域の保育園から来た園児達は、高校生が一緒に手をつないで避難場所まで移動しました。
生徒の人数確認・安全確認が終わってから、体育館で消防職員の方より指導・講評・講話が行われました。
指導・講評・講話では、日本においては「地震による災害はいつでも起こる」ということを意識して欲しい
という話がとても印象的でした。
命を守る行動ができるように、日ごろの訓練が必要なことを学びました。
講話の後、学校を代表して3年食品科学科の山村さんよりお礼の言葉がありました。
鏡消防署の職員の皆様、本日はお忙しい中ご指導いただき、誠にありがとうございました。
 カーネーション・プリムラ販売中!
カーネーション・プリムラ販売中!
本日より、園芸科学科の草花専攻生が育ててきたカーネーションを販売開始しました。
本日出荷したカーネーションは、予定より早く開花したものを販売しましたが、
一般の方への販売も致しますので、農場へお越しください。
なお、数には限りがございますので、早めの来校をお願いします。
カーネーションの出荷調整しています
品種名はテキーラ ほか3色あります。
プリムラの出荷調整です
小学生交流学習
2年生の野菜の授業で、鏡小2年生、約60名弱の生徒さんとピーマンの定植を行いました。
真剣に先生の説明を聞いていました。
高校生のお兄さん・お姉さんに教えてもらいながら楽しく植えていました。
天気も良く楽しく交流が出来たと思います。
これから植物が育っていくので小学生の皆さん、時間がある時は見に来てください
「熊日新聞コンクール高校PTA新聞の部」結果報告
熊日新聞コンクール高校PTA新聞の部で、八代農業高校PTA新聞が「優良賞」を受賞しました。
この授賞式が4月13日(土)に、熊本日日新聞社で行われ、本校の令和5年度新聞委員長に
出席して頂きました。
本校のPTA新聞委員の皆様、受賞おめでとうございます。
今年度も本校のPTA新聞活動をよろしくお願いいたします。
部活動紹介が行われました
対面式後、部活動紹介が行われました。
陸上部 なぎなた部 ウエイトリフティング部
野球部 男子バスケットボール部 女子バスケットボール部
サッカー部 ソフトテニス部 バドミントン部
卓球部
文化部
イラスト部 華道部
茶道部 音楽部 ボランティア部
専門部
被服デザイン部 食品研究部は紹介だけでした。
それぞれの部活動で個性豊かな紹介を行っていました。
1年生の皆さん、ぜひ部活動に入って高校生活を充実させましょう。
令和6年度 入学式
本日、入学式が行われました。
入学式 次第
1 開式の辞 2 国歌斉唱 3 入学許可 4 校長式辞 5 新入生代表宣誓 6 祝辞 7 来賓紹介並びに祝詞・祝電披露 8 在校生代表歓迎のことば 9 校歌斉唱 10 閉式の辞
開式
入学許可
新入生代表宣誓 家庭科 日隈さん
祝辞
熊本県議会議員 坂田 孝志 様 PTA会長 田口 真由美 様
在校生代表歓迎のことば 3年食品科学科 山村さん
1学年職員・主任主事紹介
保護者代表あいさつ
新入生退場
1学年主任あいさつ
ホームルーム
改めまして本日はご入学誠におめでとうございます。
いよいよ本日から高校生としての日々が始まります。
八代農業高校の学校生活をしっかり楽しみましょう。
令和6年度 始業式
新任式の後、始業式が行われました。
令和6年度 始業式 次第
1 開式 2 校長訓話 3 校歌斉唱 4 閉式
校長訓話では、今年度本校の教育スローガンである「GO!前へ! ~夢実現へチャレンジ~」についての説明と生徒たちへのエールが送られました。
その後、クラスの担任の先生などが発表される校務分掌発表が行われました。
校務分掌発表後は、各部より連絡があり、整容指導が行われました。
いよいよ令和6年度がスタートしました。
新たな気持ちで、今年1年、少しでも前に進めるようみんなでがんばりましょう。
令和6年度 新任式
本日、新任式が行われました。
校長先生をはじめ、8名の先生方がステージに上がられました。
川邊教頭先生により、各新任者の紹介があり、その後新任者を代表して校長先生より挨拶がありました。
在校生歓迎の言葉を3年食品科学科の山村さんが行いました。
転任された先生方、八代農業高校においで頂きありがとうございます。
そして、八代農業高校と生徒をよろしくお願いいたします。
合格者招集が行われました
本日、新入生の合格者招集が行われました。
主に、入学する時に必要な多くの書類を提出して頂きました。
新入生と保護者の皆様には、天気が悪い中来校して頂きありがとうございました。
入学式でお会いできることを楽しみにしております。
令和5年度 転退任式
本日、転退任式が行われました。
本年度は、校長先生を初め14名の先生方が転退任されました。
各先生方に一言ずつ頂き、2年食品科学科山村さんより先生方一人一人にお礼の言葉が贈られました。
その後、生徒より花束が贈られました。
その後、校歌斉唱、記念写真撮影、生徒に見守られながら退場されました。
今回転退任する先生方は勤務年数も様々ですが、八代農業高校の発展のために力を尽くして頂きました。
それぞれ新天地でご活躍されると思いますが、今後とも八代農業高校をよろしくお願いいたします。
改めまして、八代農業高校を転退任される先生方、ありがとうございました。
合格者説明会が行われました
本日、合格者説明会が体育館で行われました。
入学にあたっての説明や注意することなどたくさんの説明ありましたが、保護者の方々も新入生も真剣に聞いて頂きました。
その後、物品購入等を行ってもらい合格者説明会は終了しました。
物品購入時には、本校の部活動生が新入部員獲得のために募集をしていました。
改めまして本日お越しいただいた新入生と保護者の皆様、合格おめでとうございます。
4月から八代農業高校に登校されることを楽しみにしております。
3学期 終業式
3月22日(金)に終業式が行われました。
終業式次第
(1)開会 (2)校長訓話 (3)校歌斉唱 (4)閉式 (5)各部連絡
学校長の訓話では、フィリピンの「スモーキーマウンテン」や「スモーキーバレイ」の話があり、日本の環境がいかに恵まれている環境であるかという話がありました。
少し視野を広げて、いろいろな事を知る大切さを学びました。
今年度も終わり、来年度はすぐに始まります。この春休み期間は、来年度に向けた準備をしっかり行いましょう。
3学期 表彰式
表彰式が行われました。
表彰者一覧
第14回熊本県高校生介護技術コンテスト 優良賞
2年 福祉家庭科科 喜多川さん 増住さん 河本さん
第9回熊本県農業関係高等学校バドミントン大会 3位
2年 食品科学科 山村さん 吉岡さん 2年 農業工学科 坂口さん
1年 食農創造科 川上さん
学校長表彰
1年 食農創造科 松岡さん 2年 福祉家庭科 高田さん
令和5年度 農業クラブ校内プロジェクト発表会
最優秀賞
2年 園芸科学科 山形さん 森本さん
優秀賞
2年 食品科学科 前田さん 仲瀬さん 岩田さん 田口さん 古川さん 寳來さん 満﨑さん
優秀賞
2年 農業工学科 渡辺さん 金枝さん 村勧さん
1年間多読賞
1年 食農創造科 折戸さん 鶴田さん
1年生皆勤賞
食農創造科 赤崎さん 鶴田さん
生産土木科 原田さん 福浦さん
家庭科 荻さん 佐藤さん 高野さん 西島さん 山田さん
1年生成績優秀賞
食農創造科 有田さん 清田さん
生産土木科 中村さん
家庭科 岩本さん 白石さん
2年生皆勤賞
園芸科学科 河野さん 原田さん 古島さん
食品科学科 出田さん 村田さん
農業工学科 村勧さん
2年生成績優秀賞
園芸科学科 古畑さん
食品科学科 出田さん 藤本さん 村田さん
福祉家庭科 喜多川さん
表彰を受けられた皆さん、受賞おめでとうございました。
図書館だより更新しました!!
図書館だより3月号を掲載しています。
目次 → 学校生活 → 図書館
から見ることが出来ます。
令和5年度(2023年度)校内プロジェクト発表会
3月15日(金)に、校内プロジェクト発表会が行われました。
校内プロジェクト発表会次第
開会式 1年 食農創造科 津々路さん
農業クラブ会長挨拶 2年 食品科学科 大庫さん
成人代表挨拶 川邊教頭先生
発表上の注意 2年 食品科学科 古川さん
発表
講評 志水先生(産業教育部長)
閉会 1年 食農創造科 津々路さん
発表一覧(発表順番より)
1番 食品科学科 古来からのバトンをつなぐハトムギ物語~ハトムギ菓子の製造~
2番 園芸科学科 不知火の露地・ハウス栽培の違いによる生育・品質調査
果樹専攻班
3番 園芸科学科 ナノバブル水がシクラメンの生育に及ぼす影響
草花専攻班
4番 園芸科学科 キュウリにおける育苗ポットの違いによる生育・収量比較調査
野菜専攻班
5番 農業工学科 スマート農業の普及に向けた取り組み~次世代の新しい農業を目指して~
どの発表もとても勉強になりました。発表者の皆様お疲れさまでした。
2年食品科学科 甘夏マーマレードの製造実験
2年食品科学科の食品製造の授業で甘夏マーマレードを製造しました。
今回は、今年も日本で行われるダルメインWorldマーマレードアワード&フェスティバルに出品するマーマレードを製造しました。
各班それぞれテーマを持って、製造しました。
完成後は、みんなで試食しアンケートを行いました。
今年も、大会で銀賞以上を目指して頑張っています。
トラクタ納車式
本日、八代農業高校農場センター前駐車場にて、トラクタ納車式が行われました。
これは、JAグループ熊本様より、農業の担い手育成と地域農業の発展を目的として、自動操舵機能付トラクタ(KUBOTA SL54)一式を贈呈して頂き、今回本校へ納車いただくこととなりました。
納車式次第
開会 志水農場長
挨拶 川邊教頭先生
トラクタ紹介 JA熊本経済連 関係者 様
生徒代表挨拶 農業クラブ副会長 農業工学科2年 坂口さん
閉会
農業関係学科の生徒も寄贈の意義を改めて確認し、将来の八代及び熊本県の農業発展に寄与する一員としての自覚を持つとともに、トラクタの安全を祈念する機会となりました。
 【農業工学科】熊本県庁現場見学バスツアーに参加
【農業工学科】熊本県庁現場見学バスツアーに参加
3/13(水)公務員への就職を希望する生徒が熊本県庁現場見学バスツアーに参加しました。
昨年5月にできたばかりの熊本県庁防災センターで、建設された経緯や施設の概要について、熊本地震発生当時に総指揮を取られた方からご説明していただきました。

その後、高森線4車線化区画整備事業現場へ行き、復興の様子を見学しました。

次に宇城市の農地区画整備事業現場を見学し、圃場の乾田化や環境改善についてご説明していただきました。

最後は、熊本天草幹線道路の天草未来大橋を見学しました。事業の全体像や地域の方の思いなどを学びました。

バスツアーに参加して熊本県職員の仕事について知ることができました。これからの進路選択に役立てていきます!
令和5年度(第42回)熊本県高等学校教職員サッカー大会が行われました
3月9日に、嘉島町にあるCOSMOSフットボールセンターで、熊本県高等学校教職員サッカー大会に参加しました。
本校は、第1試合目に北稜高校と行い、第2試合目に熊本盲学校Aと対戦しました。
天気も良く、気候的にも絶好のスポーツ日和となりました。
様々な年齢層の先生方が参加され、男女で協力して交代しながら試合に臨みました。
大きなケガもなく無事試合を乗り切れました。選手の皆さんお疲れさまでした。
良いリフレッシュの機会になりました。
 最後のホームルーム
最後のホームルーム
卒業式が終わり、各クラスに戻ってきました
各クラスでは最後のホームルームが行われています。
1人1人、担任の先生から卒業証書を受け取ります。

卒業証書を受け取り、これまでの感謝の気持ちやこれからの意気込みなど
1人1人がクラスメイトの前で話しました
八農で過ごした3年間はいかがだったでしょうか。
様々な制限がある中で入学・・・
少しずつ、感染症対策を講じながら実施してきた学校行事。
ここで過ごした時間、友人は一生の宝物になると思います。
これから新しい生活がはじまる皆さんですが
大変なこと、楽しいこと、嬉しいこと、、、いろんなことが待ち受けています。
「自立」というお話があったのは覚えていますか???
困ったとき、悩んだときは一度立ち止まって、
周りの人、もちろん八農の先生でも構いませんので
声をだして「助けてください」といえる人になってほしいと思います
令和5年度卒業証書授与式
本日、卒業証書授与式が行われました。
式次第
1 開式の辞
2 国歌斉唱
3 卒業証書授与
4 校長式辞
5 熊本県教育委員会あいさつ
6 祝辞
7 来賓紹介、祝詞・祝電披露
8 在校生総代送辞
9 卒業生総代答辞
10 唱歌「蛍の光・仰げば尊し」
11 校歌斉唱
12 閉式の辞
卒業生入場
卒業証書授与
来賓紹介、祝詞・祝電披露
在校生総代送辞 (2年食品科学科 山村さん)
卒業生総代答辞(3年農業工学科 内田さん)
保護者代表挨拶
卒業生退場
卒業式後は、教室に戻り保護者と一緒に最後のHRへと各学科移動しました。
3年生の生徒の皆様、そして保護者の皆様ご卒業おめでとうございます。
また、お忙しい中参加して頂いた来賓の皆様、本日は誠にありがとうございました。
 スイートコーンの播種
スイートコーンの播種
スイートコーンの播種を行いました
今年は少し早めに収穫できるように、早めの播種です
品種も昨年から変更し、チャレンジです
丁寧に実習を行ってきます
協力してできたかな??
年度当初を思い出すと、今は見違えるくらい集中して取り組むことができるようになったと思います
2年生になっても、良いところをもっと伸ばしていってね
来週に定植を予定していますが、気温と天気が心配です
おいしいスイートコーンが収穫できるように管理頑張っていきましょう
同窓会入会式
同窓会入会式が行われました。
式次第
1 開会 2 同窓会長あいさつ 3 入会者代表宣誓 4 祝辞 5 記念品贈呈
6 お礼の言葉 7 同窓会長賞授与 8 閉会
2 同窓会長あいさつ
3 入学者代表宣誓
4 祝辞
5 記念品贈呈
7 同窓会長賞授与
8 閉会
同窓会入会式後
同窓会入会おめでとうございます。
今後も八代農業高等学校をよろしくお願いいたします。
 厳粛に・・・・
厳粛に・・・・
本日は明日の卒業式に向けて予行が行われました
まずは唱歌の練習からです
国歌、校歌、蛍の光、仰げば尊し。
感染症に気をつかい、換気を行いながら、声を出しての歌唱です
校歌は特に声がでていて、素晴らしい!!
入退場の練習も行いました
今年度は1.2年生も参加します!!
これまでの感謝の気持ちを込めて、気持ちよく送り出してください
3年生のみなさん、明日はいよいよ卒業式です。
これまでの高校生活を振り返ってみて、高校生活いかがだったでしょうか?
楽しかったこと、大変だったこと、、、、いろいろあったけども
八農でよかったなあと思える、卒業式になりますように
 トラクターを寄贈していただきました!
トラクターを寄贈していただきました!
2月27日に、JA会館熊本にて
JAグループ熊本様よりトラクターの寄贈をしていただきました
寄贈していただいたのは、
「クボタトラクター SL54及び機材一式」です
本校にあるトラクターの約2倍もしくは2倍以上の働きをしてくれる新トラクターです!!
これから生産土木科を中心にスマート農業の学習と地域の方々との研修用として
活用させていただきたいと思います
また納車後の様子などをブログにアップしていきたいと思います
JAグループ熊本様、大切に使用させていただきます、
寄贈していただき、本当にありがとうございました。
 卒業式に花を添えるのは・・・?
卒業式に花を添えるのは・・・?
いよいよ明日は卒業式です!!
卒業式に卒業生がつけるコサージュを1.2年生の
三部会役員の生徒たちが作成してくれました
しっかり説明を聞いて作成していきますよ
メインになるお花はガーベラを使用します
学科ごとに色別に作ります!!
作成しながら、「もう先輩たちと会えなくなると思うと寂しいです」とポツリ。
予行練習でウルウルしてしまう在校生もいたようです。
完成版は明日の卒業式で見てみてくださいね
3学年表彰式
本日、卒業生表彰が行われました。
卒業生表彰一覧
財団法人産業教育振興中央会長賞 食品科学科 森下さん
(令和5年度専門高校等御下賜金記念優良卒業生) 福祉家庭科 大羽さん
全国農業高等学校長協会賞 園芸科学科 江﨑さん
食品科学科 尾崎さん
農業工学科 上田さん
全国高等学校家庭クラブ連盟賞 福祉家庭科 濱田さん
熊本県学校農業クラブ連盟賞 食品科学科 森下さん
園芸科学科 藤本さん
熊本県高等学校文化連盟図書部会 図書委員功労賞 園芸科学科 藤本さん
食品科学科 藤原さん
熊本県がんばる高校生 農業工学科 荒川さん
熊本県高等学校体育連盟賞 園芸科学科 池田さん
農業工学科 荒川さん
福祉家庭科 白濱さん
熊本県高等学校保健会長賞 福祉家庭科 福浦さん
福祉家庭科 丸山さん
熊本県高等学校文化連盟文化功労賞 食品科学科 福島さん
熊本県高等学校野球連盟賞 食品科学科 上野さん
全国高等学校 家庭科技術検定 技能賞 被服(洋服)製作1級 福祉家庭科 丸山さん
学業成績優秀賞
農業工学科 荒川さん 農業工学科 上田さん 農業工学科 内田さん
福祉家庭科 大羽さん 福祉家庭科 濱田さん
皆勤賞
園芸科学科 村中さん 食品科学科 松永さん 農業工学科 上田さん
農業工学科 村川さん 福祉家庭科 大羽さん
表彰を受けた3年生の皆さん、おめでとうございました。
1年食農創造科 ロールケーキ実習
1年食農創造科の生徒が食品製造の授業で、ロールケーキを作りました。
まず、生地を焼いていきます。
生地が出来上がったら、中に生クリーム入れ巻いていきます。
その後、冷蔵庫で冷やし、食べやすい大きさに切っていきます。
味見をした生徒たちは、とても満足した表情でした。
みんなうまく巻けたようです。
図書館だより更新しました!!
図書館だより2月号を掲載しました。
目次の
学校生活 → 図書館
よりご覧ください。
生産土木科1年農業法人視察研修
2月21日(水)に八代地域の農業法人等に視察研修に行きました
ご協力いただいた事業所
1️⃣㈱トマトドリームカンパニー 様
2️⃣㈱たかき 様
3️⃣カネムマンソーセージ 様
大規模な施設栽培、バナナのお土産、燻製の試食など、見て・食べて学ぶことができました
八代農業高校が地域から期待されていることを改めて実感する研修となりました
今後も企業と連携し、八代地域の発展と農業に関する知識と技術を高めていきます
令和5年度 八代市高校生地方創生会議
2月25日(日)に八代市役所にて、八代市高校生地方創生会議が開催されました
八代地域の6校が参加し、様々な企画提案や取組発表がありました
本校からは、農業工学科2年大石さん、皆吉さんがスマート農業を通した農業の発展と稼げる農業について発表を行いました
参加者からも建設的なご意見をいただくことができ、今後の活動も意欲的に行っていきます
 メイク講習!!
メイク講習!!
2月22日は3年生の登校日でした
今日は女子生徒を対象に、メイク講習を実施しました
講師として、熊本ベルェベル美容専門学校より杉本様、井上様にお越しいただき
4月からの新生活に向けて、ナチュラルメイクについて講習をしていただきました
人の第一印象を決めるのは3~5秒と言われ、特に眉毛の形で
相手にいろんなイメージを与えてしまうそうです
実際に眉毛の黄金比で、書いてみました
次はアイシャドウの塗り方です。
様々な色のあるパレットから、自分の顔のタイプになじむ色を見つけます
特別に生徒にモデルになってもらい、デモンストレーションを
行ってもらいました
友達同士でメイクをしたり、とても楽しそうです
講師の方からのアドバイスを受けながら、メイクをしていきます
手慣れている人もちらほら、、、
生徒のみなさん、今回のメイク講習いかがでしたでしょうか・・・
卒業をして、メイクをする機会がとても増えると思います。
今回講習のなかにもありましたが、お肌のピークは20~25歳だそうです。
スキンケアも忘れず、身だしなみのひとつとして
この講習が役に立ってくれると幸いです
 なすの播種を行いました!!
なすの播種を行いました!!
2月に、この大雨・・・
これからの栽培が心配になります
1年食農創造科では、次年度に向けてナスの播種を行いました
このナスは来年度の農業と環境の授業で管理していきます
セルトレイに用土を入れていきます
用土に水を含ませて、落ち着いたら・・・・
割りばしを使って、1センチの深さの穴を開けていきます
ナスの小さい種を一つずつ、播種していきます
上から、軽く覆土をします
覆土したら、灌水をして終了です
今回、2種類のナスを播種しました
新しい1年生は、このナスを管理したり、収穫したりしていきます
着々と来年度の準備をしています・・・
次はスイートコーンです
 【農業工学科】ドローン講義
【農業工学科】ドローン講義
農業工学科2年生が水中ドローンとドローンによる測量の講義を受講しました。
講師として、株式会社ベルポート宇土様、CLIMAX様にお越しいただきました。
生徒たちは、水中ドローンの活用場面や操作について体験を交えて講義を受けました。
また、ドローンによる測量について講義をしてただき、自動操縦やデータ処理について学習しました。
様々な場面で活用されているドローンの可能性を学ぶことができ、これからの学習にも生かしていきたいと思います!
講師の皆様、ありがとうございました。
令和5年度宇城地域くまもとふるさと食の技交換会
本日、宇城市保健福祉センターで宇城地域くまもとふるさと食の技交換会が行われました。
本校から食の名人である岩野先生が講師として招かれ、マーマレードの実演紹介が行われました。
また、もう一人講師として、同じく食の名人である飯田さんによる生姜加工品の実演紹介がありました。
各実演紹介の時には、参加者の皆様からたくさんの質問があり、とても熱心に実演紹介を見られていました。
その後、試食と情報交換会が行われました。
参加者の皆さんも食の名人の方で、食育についてなどそれぞれの方の思いを聞くことができました。
また、食を通してどのように地域貢献できるのかなどを考える良い機会となりました。
本日は、お招きいただきありがとうございました。
油谷分収林②
本日、本校の油谷分収林実習地の整備を行うために、何人かの先生方で行ってきました。
草や雑木や竹などで荒地になっています。
この場所を草刈り機やチェーンソー、ノコギリや剪定ばさみなどを使ってきれいにしました。
今回は、倉庫の周辺だけでしたが、雑木がからまり、つる性の植物もたくさんあり、なかなか大変な作業でした。
管理された先生方、お疲れさまでした。
八代農業高校名物「万能タレ」製造しました!!
今年度最後の万能タレを2年食品科学科の生徒が製造しました。
万能タレは、八代のトマトと梨のピューレを基本とし、ショウガやニンニク、レモン、タマネギ、
ピーナッツなどが入っており、料理のタレとして何にでも使える焼き肉のタレ風に仕上げたソース
です。パスタにそのままかけてもおいしいソースで、様々な料理にも活用できます。
この万能タレの中に、八代の特産品が詰まっています。
ぜひ1度食べてみてください。
学校の正面玄関で販売しております。
よろしくお願いいたします。
2年食品科学科 課題研究成果物発表会
2年食品科学科の生徒が課題研究で行ってきた課題に沿ったお菓子等を製造し、
成果物として評価をしてもらう成果物発表会が行われました。
それぞれ、1年間取り組んだものを評価してもらいました。
食品科学科の2年生の皆さんお疲れさまでした。
令和5年度(2023年度) 熊本県産業教育振興会 八代支部会が行われました。
本校の視聴覚室で、熊本県産業教育振興会 八代支部会の会議が行われました。
会議の場をお借りして、3年食品科学科の生徒による、マーマレードの紹介をさせて頂きました。
また、会議後試食等もして頂き、誠にありがとうございました。
3年福祉家庭科 子育て支援センターへのプレゼント
3年生はいよいよ卒業間近になりました。
これまで「子どもの発達と保育」の授業で鏡子育て支援センターとの交流会を行ってきました。5回の交流会を通して、子どもの発達について、保育について、子育て支援の重要性・・・など
いろいろなことを学んできました。
そのお礼として、子育て支援センターに来られる赤ちゃんたちへ赤ちゃん用スタイを作りました!!オーガニックコットンの生地を使ってミシンで一人一枚ずつ心を込めて縫いました。
スタイにはメッセージも添えて・・・
赤ちゃんやパパママさんが喜んでくれるとうれしいなぁ・・・と思います
3年生はもう卒業ですが、来年度も交流を続けていけると嬉しいです。
どうぞよろしくお願いします。
1年食農創造科 フォカッチャ作りました
1年食農創造科の生徒が、食品製造の時間にフォカッチャの製造を行いました。
フォカッチャは、イタリア生まれのパンの名称です。
まず、材料を混ぜてこねていきます。
この後、ホイロで一次発酵させます。
一次発酵終了後、生地を計量し分割して、広げ、二次発酵させます。
二次発酵後、用意されたソースやホウレン草やチーズなどを乗せて、焼きます。
出来上がりです。
みんなうまく焼けていました。おいしかったです。
 3年生学年集会
3年生学年集会
3年生の学年末考査が終わり、最後の学年集会です。
2月から3年生は家庭学習期間に入ります
集会では、
★体調管理に気を付けて過ごすこと
★2月の登校日の確認
★残されたことを計画的に行うこと(自動車学校等々・・・)
について、学年主任からお話がありました
これが高校生活最後の春休みです・・・
4月からは皆さん、新生活が始まります。
この家庭学習期間で、様々な準備を行い新生活に備えてくださいね
また2月に計画されている登校日では
金融の話、スーツの着こなし、身だしなみ(メイク講習)などなど
4月に向けてどんどん動いていきますよ!!
図書館だより更新しました!!
図書館だより更新しました。
学校生活 → 図書館 をクリックされると見れます。
3年食品科学科 課題研究発表会
1月30日(火)、食品科学科3年生の課題研究発表会が行われました。
それぞれのテーマに沿って、1年間研究してきたことをプレゼンテーションしました。
また、発表後は1・2年生より質問や感想を述べられ、3年生も一生懸命返答していました。
この課題研究を経て、それぞれが「卒業後のやるべきこと」への取り組み方や研究の仕方等、
多くのことを学んだようです。
課題研究で学んだことを活かして、今後の進路で頑張って欲しいと思います。
3年食品科学科の生徒の皆さん、発表お疲れさまでした。
 1人1畑1研究発表会!!
1人1畑1研究発表会!!
夏休み前から活動してきた1人1畑1研究も、この発表を持って終わります・・・
2人もしくは3人で班を作り、
協力しながら行ってきた活動ですが、まとめは個人で行い、
発表は役割を決めて、班で行います
みんなの前で発表するのはとても緊張しますね
台本を作成し、とても分かりやすい発表もあり、まとめ方が上手です(^O^)/
スライドの文字色や大きさを変えて、見やすくしたり
アニメーションを付けたりと工夫したものもありました
発表に対しての質問も出ました!!
グラフからしっかり結果を読み取り、
わかったこと、気づいたことに対して、調べ学習を行い、
理解を深め、知識を身につけることができていたのではないかと思います
中には、まだまだ改善の余地がある発表もありましたが、
まずは、プロジェクト学習(①課題の設定②計画の立案③実施④反省・評価)の
一連の流れを経験することができたのではないでしょうか
今後もこのような活動が続いていきます!!
この経験を生かして、主体的に活動していきましょうね
福祉家庭科・家庭科1,2年合同授業 ベッドメイキングをしました!
家庭科、福祉家庭科です!
今回は、福祉の授業でベッドメイキングをしました
2年生が1年生に手順を教えます。
2年生は、どのようにすればわかりやすく伝わるか、教えることの難しさを学んだようです。
1年生は、シーツの角のたたみ方や手順、声かけを覚えることが難しかったようですが、先輩達から教わって嬉しそうでした
学年を超えて交流することでお互いに新たな視点に気づくことがありますね!
これからも介護の技術や知識を学んでいきましょう!
家庭科1年 防災食を作りました!~ポリ袋調理~
1年家庭総合の授業では、防災について学んでいます。
能登半島地震が起こり、熊本地震の経験を振り返りながら自分たちに何ができるのかを考えます。
実際に災害が起きた時にどのように行動するのか、非常時に備えておくものは何かを調べて話し合います。
今回は、災害時に活躍するポリ袋を使って、カレーを作りました
本番を想定してペットボトルの水を使っていきます。
無洗米やコンロを使い、電気や水が止まってもご飯が炊けるようにします。
肉は缶詰の焼き鳥を使いました。ツナ缶やサバ缶なども活用できます
材料をポリ袋の中に入れて、沸騰したお湯の中に浸して煮込みます。どのような仕上がりになるかな・・・?
できあがりました
米も上手に炊けていますカレーは具に火が通りにくかったようなので、細かく切ると良さそうですね!
今後も防災に対する意識を高めていきましょう!
八農名物 トマトケチャップ製造しました!!
2年食品科学科の生徒がトマトケチャップを作りました。
初めてのトマトケチャップ製造でしたが、みんなで協力しながらケチャップの充てんを行いました。
現在、学校の正面玄関で販売しています。
よろしくお願いします。
 3年園芸科学科 課題研究発表会!!
3年園芸科学科 課題研究発表会!!
1月22日に、3年生園芸科学科の課題研究発表会が行われました
約1年間かけて、研究や実習、調査を行ってきました
みんな堂々と発表できていました
来月には2年生も発表を控えています。
今後の発表の参考になったかな???
★1人1畑1経営~白菜無双・CRお気に入り~
★イチゴの優良品種の比較研究
★1人1畑1経営~あきさくほうれん草~
★1人1畑1研究~スイカの品種比較~
★興津早生の着果位置の違いが生育・品種に及ぼす影響
★太秋柿の着果個数の違いが生育・品質に及ぼす影響
★ブドウの1房粒数の違いが生育・品質に及ぼす影響
★温州ミカンの着果位置の違いが生育・品質に及ぼす影響
クラスの半数が卒業後は、就農や農業大学校進学など、
これからも農業に携わります。
発表後の先生方からの質問も、今後の農業人生に繋がるようなものばかりだったように思います。
個人的な感想にはなってしまいますが・・・
この日のために、多くの準備を行ってきた三年生。
日々の実習の中での、研究やまとめ、そして発表練習・・・
とても積極的に行動していたように思います。
発表はもちろんですが、その過程で頑張ることができた3年生に感動した発表会でした
3年生のみなさん、お疲れ様でした。
3年福祉家庭科 選択「食文化」 節分~巻きずし作り~
2月3日は節分です。節分は、一般的に邪気を払い、無病息災を願う行事、といわれています。近年は「豆まき」の他に、恵方巻を食べる文化が広がっています。節分に運気が良い方角(恵方)を向き、願い事をしながら太巻きを黙々と最後まで食べるというものです。2024年は「東北東」です。
授業では、太巻き寿司とサラダ巻きの2種類を作ってみました。
太巻き寿司の具は、かんぴょう・しいたけ・卵焼き・きゅうり・桜でんぶです。
サラダ巻の具は、レタス・ツナ・カニかまぼこ・卵焼き・きゅうりです。
初めて作りましたが、中の具が出ないように巻くのが難しかったです。
恵方巻は切らずに食べることが多いですが、授業では切ってみることにしました。
中の具を押しつぶさないように、慎重に切ります。
上手に巻けました。中の具は何でもいいと思います。皆さんも作ってみませんか。
「食品微生物」の授業で抗菌性物質の実験とキノコの観察を行いました
2年食品科学科の「食品微生物」の授業で抗菌性物質の実験が行われました。
抗菌性物質であるニンニクを使った実験です。
また、ヒラタケとナメコの菌を培養しています。
うまくキノコが出てくると良いですが・・・
3年福祉家庭科 ~保育園実習~
今日は楽しみにしていた保育園実習でした。
パネルシアターを練習して、今日は子どもたちの前で披露します。
クラスごとにお土産も作りました。喜んでくれるかドキドキです。
保育園に着いたら早速園庭に出て子どもたちとおにごっこや砂遊び。
一緒に体操や縄跳びもしました。抱っこーー!おんぶーー!となついてくれてうれしかったです。
ホールでのパネルシアターは「七ひきのこやぎ」「花咲かじいさん」「さるかに合戦」をしました。
2時間半という短い時間でしたが、忘れられない貴重な経験ができたと思います。
帰る時、子どもたちの中には「帰らないでーー!と泣いてくれる子もいました。
パネルシアターやお土産、喜んでもらってがんばって準備した甲斐がありました。
鏡保育園の皆さま、どうもありがとうございました!!
1年食農創造科 パイ作り
1年食農創造科の生徒たちが、食品製造の授業でバイの作り方について学びました。
振るった小麦粉にバターを混ぜ細かくしていきます。
中心に水を入れ、混ぜていきます。
一度ラップにまいて、生地を冷凍庫で寝かせます。
寝かせた後、生地を練(ね)っていきます。
その後、平らに伸ばし、パイの大きさに切っていきます。
ストロベリージャムかブルーベリージャムを入れます。
卵をぬってオーブンで焼きます。
みんな上手に焼き上がりました
 ドローン講習会が行われました!!
ドローン講習会が行われました!!
1月12日、本校の水田で、ドローン講習会が行われました
講師には、グリーンテック株式会社 八代営業所より印口様と岡本様をお呼びし
生産土木科の1年生を対象に、ドローン講習会を実施しました
大きいですね!!
この大きさで最大、粒剤で40kgほど搭載できるそうです!
そして、最大時速15kmで散布できます
いつもは動力噴霧器を背負って、ほぼ半日がかりで散布するのですが、
このドローンを使えば、約1時間ほどで終わるそうです
ドローンのオペレーターの方に、操縦の方法や仕組みを教えてもらいながら
しっかり学びます
実際に、土壌改良剤を搭載し、散布を行ってもらいました
近くでみると、とても迫力があり、そしてかっこいい
GPSを利用し、正確に散布でき、無駄に散布しないので
とてもコストカットです
今回は、実技講習も兼ねていますので、
生徒たちも、講師の指導の下、安全に講習を行いました
農業分野において、ICTやIoTを活用したスマート農業が普及しつつある中で
ドローンは重要なツールになっています。
高齢化や後継者不足で人員が不足する中で、これからドローンは必須になってくるのでは
ないかと思います
16歳以上ならば、免許が取得できますので、
正しい知識と技術を持って、さまざまな分野で
活躍してくれる八農生がでてきてくれると嬉しいですね
印口様、岡本様、講習をしていただき本当にありがとうございました
 三部会、新会長・副会長任命式が行われました
三部会、新会長・副会長任命式が行われました
12月に行われた三部会役員改選で、生徒の投票によって当選した
新会長と副会長の任命式が行われました
任命式のあとは
新旧会長と副会長の挨拶がありました
旧会長・副会長からは、この一年間の感謝の気持ちと今後の八農
三部会へのエールが送られました
旧会長・副会長のみなさん、一年間大変お疲れさまでした
そして、新会長・副会長からは、これからの意気込みと八農をよりよい学校にしたいという
強い思いが伝わってきました
八農生みんなで力を合わせ、八農を盛り上げてきましょう
 表彰式が行われました
表彰式が行われました
NITFファッションデザインコンテスト2023で
本校の福祉家庭科3年の丸山さんが奨励賞を受賞しました
おめでとうございます
 3学期が始まりました
3学期が始まりました
1月9日からいよいよ3学期です
17日間の冬休みはどう過ごしましたか?
2024年が始まったとき、今年はどんな一年になるだろうか、
自然災害や大きな事故が少ない一年になればと願っていたのですが、
元旦には石川県を震源に大地震、2日には飛行機の事故。
どれも胸が痛くなる報道ばかり。
しかし、飛行機の事故では、旅客機に乗っていた約400名の命が
客室乗務員の方々の冷静な判断と日頃の訓練によって守られました。
何がいいたいかというと・・・
まだ起こるかわからないことに対して万全の準備をしておくことで
もし万が一のことが起きても対応できるということです。
4月になると皆さん新生活、新学年、新天地・・・
この3学期に4月からの新生活のために準備をしておくと
スムーズに行動できるのではないでしょうか
教頭先生からのお話のあとは
教務、進路、生徒指導、教育支援の先生方からお話がありました。
★規則正しい生活を
★将来のこと・・何をしたいのか、思っていることを言葉にして伝えよう
今年度もあと少し・・・
体調管理にも気を付けて4月に向けて頑張っていきましょう
令和6年がスタートしました
明けましておめでとうございます
令和6年も八代農業高校をよろしくお願いいたします
本日から、令和6年(2024年)の仕事がスタートしました。
学校では3学期に向けての会議や課題考査の問題作成、部活動指導など
多くの先生方が笑顔で仕事に取り組まれています。
来週から3学期が始まります。
3学期の始業式、生徒の皆さんと会えることを楽しみにしています。
令和5年度 仕事納め式
本日、仕事納め式を行いました。
まず、学校で栽培したもち米を使って餅つきを行い、お供え用の鏡もちを作りました。
「杵と臼を使っての餅つきは初めての体験」という職員もいましたが、
無事にお供え用の鏡餅を作り、本校玄関に飾ることができました。
また、熊本県知事から認定されている「くまもとふるさと食の名人」である
I先生手作りの甘酒で乾杯をし、仕事納め式を行いました。
仕事納め式では、学校で栽培した野菜を使った味噌汁を食べながら
令和5年の反省や新年に向けての展望の話で盛り上がっていました。
皆様、本年(2023年)も大変お世話になりました。良いお年をお迎えください。
また、来年(2024年)もよろしくお願いいたします。
令和5年 学校表彰
令和5年の学校表彰の紹介をします。
まず、令和5年度熊本県教育功労(優秀教職員)の表彰の受賞です。
この賞は、日頃から教育活動に積極的に取組み、優秀な成果をあげた
教職員について表彰する制度です。
本校の平田先生が、果樹栽培並びに農業鑑定競技指導において
優れた指導力を発揮されたことが評価され受賞されました。
平田先生、優秀教職員の受賞おめでとうございました。
これからも、八代農業高校発展のために
熱いご指導をよろしくお願いします。
また、これまで取組んできた租税教育についての感謝状を
八代税務署様より頂いております。
みなさんも知っていると思いますが、「納税は国民の義務」です。
今後も、次代を担う生徒等が、民主主義の根幹である租税の意義や役割を
正しく理解し、社会の構成員として税金を納め、その使い道に関心を持ち、
さらには納税者として社会や国の在り方を主体的に考えるという自覚を育
てることを目的に、租税教育を継続していきます。
令和6年も、生徒・先生方の明るいニュースが報告できるように、
八代農業高校一丸となってがんばります!
 門松作り!!
門松作り!!
クリスマスは楽しく過ごせたでしょうか
八農では・・・お正月の準備が始まっています
昨年も八農の正面玄関に立派な門松が飾られましたが、
今年はレベルアップして、門松作りが行われました
昨年より、松や南天、梅の木がボリュームアップです!!
どちらも八農の先生方が作られています。
縄の結び方や縄の巻き数、竹の配置・・・
どれも由来があります。
これを機にぜひ調べてくださいね
 2学期終業式
2学期終業式
表彰式が終わり終業式に移ります
まずは校長先生からのお話です。
2学期はいかがだったでしょうか。
農業クラブ全国大会の運営、八農祭、修学旅行、進路決定、クラスマッチ・・・
本当に行事の多い2学期でした。
みなさんは役割を持って、行動することができたでしょうか。
委員会としての役割、クラスの中での役割・・・
2学期は生徒の皆さんが1人1人の役割を理解し、行動できたことで
それぞれの行事が円滑に行われたのではないでしょうか。
これからの学校生活で充実した日々を送るために、
自分自身の役割をしっかり理解し、行動してみてくださいね
クリスマスプレゼントとして、プリントが配られました。
社会に求められる事・人材、そして敬遠したくなる人材の特徴についてのプリントです。
あまりピンと来ていない生徒もいるように見えましたが・・・
特に3年生はしっかり読み込んでください!!
社会に出るまであと3か月ほどです、この冬休みのうちに心の準備をしておいてくださいね
1・2年生、これまでの行動を振り返り、残りの学生生活で少しでも社会に求められる人材になれるよう
努力しましょう
できることはこれからどんどん伸ばし、できないことはできるように少しずつ頑張っていきましょう
終業式後に、教務部、進路部、生徒部、教育支援部から
2学期を振返っての話や冬休みの過ごし方等についての話がありました。
2学期の終わり、そして1年の終わりです。
自分ができることや課題が多く見つかったのではないかと思います。
振り返りながら、新しい1年を迎えてください。
今年も八代農業高校の教育活動にご協力いただき、大変ありがとうござました。
来年もよろしくお願いいたします。
皆様、よいお年をお迎えください。
 2学期終業式~表彰式~
2学期終業式~表彰式~
12月22日、2学期の終業式が行われました!
まずはじめは、2学期に様々な場面で活躍した生徒のみなさんの表彰です
★第74回日本学校農業クラブ全国大会 令和5年度熊本大会 農業鑑定競技
農業の部 優秀賞 園芸の部 優秀賞 園芸の部 優秀賞
★第20回 田山淳朗賞 高校生ファッション画コンテストin九州・沖縄
奨励賞
★令和5年度熊本県高等学校ウエイトリフティング競技新人大会
女子55kg級2位
★高校生フラワーコンテスト
フラワーアレンジメントの部 第一位
★第36回やつしろ全国花火競技大会(学生ボランティア)
感謝状(大会運営)
★2学期多読賞
みなさんの頑張りが、励みになり、3学期もそれぞれの場所で活躍し、そして輝いてほしいです
令和5年度 クラスマッチ
本日、体育館でクラスマッチが行われました。
クラスマッチの競技はドッジボールです。
女子は、A~Iの9チーム、男子は職員チームを含めたA~Iの9チームに分かれて行われました。
男子も女子も制限時間いっぱいまで白熱した試合を行っていました。
職員チームも生徒達に負けじと本気の戦いをしていました。
最後に、職員チームと生徒たちの男女混合チームによるエキシビジョンマッチも行われました。
先生と生徒達の対戦は他の試合とは違う盛り上がりがありました。
その後閉会式が行われ、表彰が行われました。
優勝
男子 1年生産土木 Eチーム 女子 1年食農創造科・家庭科合同 Dチーム
準優勝
男子 3年食品科学科 Iチーム 女子 2年農業工学科・福祉家庭科合同 Hチーム
3位
男子 職員チーム Aチーム 女子 3年福祉家庭科 Bチーム
という結果でした。
皆さまお疲れ様でした。
3年福祉家庭科(食文化)おせち料理づくり
もうすぐお正月です。お正月にはおせち料理を作っていただきますが、最近は手作りのものを食べることも少なくなりました。3年福祉家庭科「食文化」選択者は、おせち料理に込められた願い事や意味を調べた後、実際におせち料理づくりに挑戦してみました。
今回は、伊達巻き・栗きんとん・紅白なます・ぶりの照り焼き・煮しめ・黒豆(市販)です。あまり食べ慣れないものなので、できあがるのか不安な点がありながらも、このような出来栄えになりました。
中庭に植栽してある「南天」も添えました。「難を転じて福となす」にかけられ、災難を避けるといわれる縁起ものです。
おせち料理には人の願いが込められています。来年もよい年になりますように!!
3年福祉家庭科 食文化「米粉講習会」
12月8日に米粉インストラクターの河野先生に来校いただき、米粉のシフォンロールケーキを教えて頂きました。
これまでは小麦粉を使ってお菓子やパンを作ってきました。米粉はお菓子以外にも様々な料理に使用できるというお話を聞き、初めて米粉を使用する生徒は驚いていました。
米粉はとてもきめが細かく、小麦粉のようにふるいにかけなくてもそのまま使用できました。
生クリームとイチゴを贅沢に使い、おいしそうな米粉シフォンロールケーキができあがりました。
河野先生、ありがとうございました!!
 油谷分収林ってご存じですか??
油谷分収林ってご存じですか??
本校には、油谷分収林という実習地がありますが、ご存じでしょうか
先生方の中にも、「知らない!どこにあるの?」と思われているかもしれません
住所的には、氷川町にあるのですが、学校から車で約15分くらいで到着します
以前(20年前くらい??)は学校から自転車などで現地に向かい、
果樹の授業や草刈りなど、一日がかりで実習をしていたようです。
今日は、実習室の中の片づけを行うために
先生方で行ってきました
寒波の影響で、雪が降る中での作業でしたが・・・
以前使用していた、選果機です!!
トラックに、机や鎌などを積み、学校に戻ります
約20年前に卒業したS先生も、「当時実習で斜面の草を刈った記憶はあるが、
どこだったかな???」と
山道を歩きながら、思い出の斜面を探されていました
3年福祉家庭科「調理」~クリスマスランチ~
ある日、3年福祉家庭科の調理選択の生徒が素敵な招待状をくれました。
なんと素敵なお誘いでしょう!!
当日ワクワクしながら、調理室に行ってみると・・・
すごいクリスマス料理ができあがっていました!!!
献立を事前に自分たちで考え、作り方を調べ、当日2~4限の授業を使って料理を作り上げたそうです。テーブルコーディネートもクリスマス飾りを持参して自分たちで作り上げたそう。
テーブルクロス(ライナー)は布の端をミシンで縫って作っていました。
素敵なクリスマス飾りと美味しそうなお料理に感激です!!
昼休みの短い時間でしたが、とっても美味しいお料理をいただいて、
なんだか心温まる和やかな時間になりました。
心のこもったお料理やおもてなしは人の心を癒してくれます。
今年のクリスマスは家でいつもより手の込んだ美味しい料理を作りたいなと思いました。
クリスマスケーキは1週間前の米粉講習会で米粉インストラクターの先生に教わったブッシュドノエルをアレンジしたそう。
この写真は米粉講習会で作ったブッシュドノエルです。
3S調理選択者はこの1年で調理の技術が格段に上がっています。
夏には家庭科技術検定1級(食物)も取得することができました。すごい成長ですね!!
素敵な時間をありがとうございました。